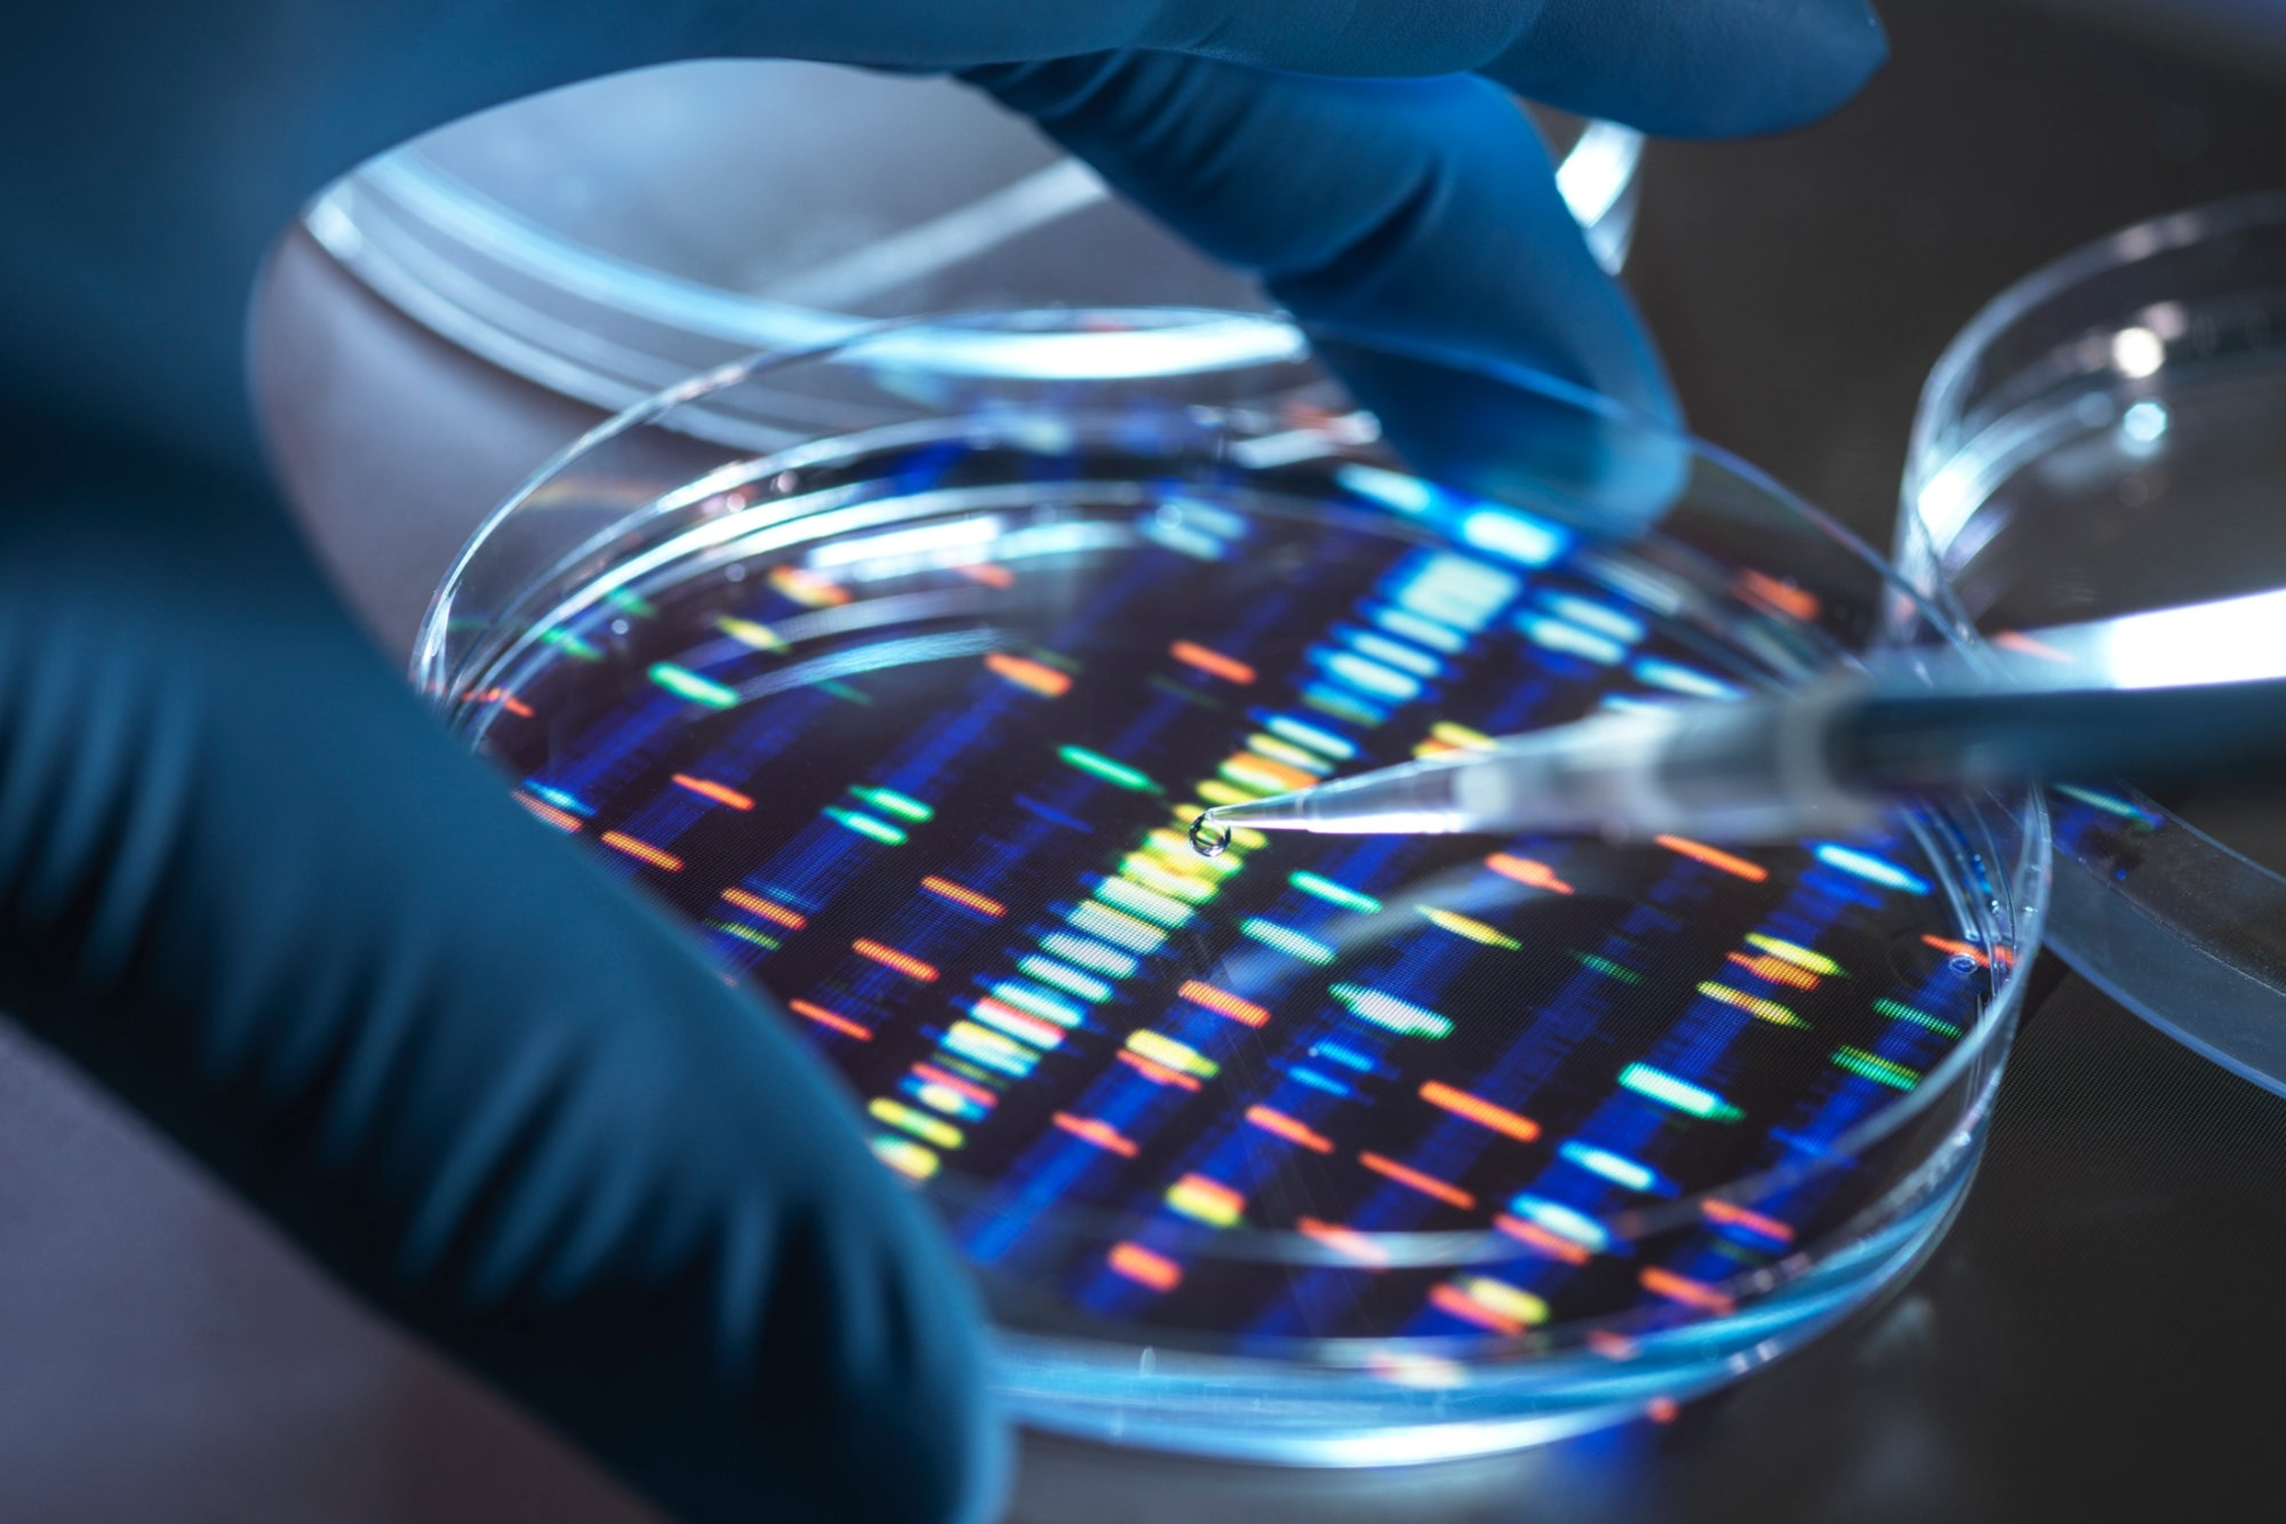

What Biotechnology's Paradigm Shift Means for Businesses
Published on January 9, 2023
Technology is transforming biotechnology and biopharmaceuticals, both in research and development and manufacturing.
Technology is transforming biotechnology and biopharmaceuticals, both in research and development and manufacturing.